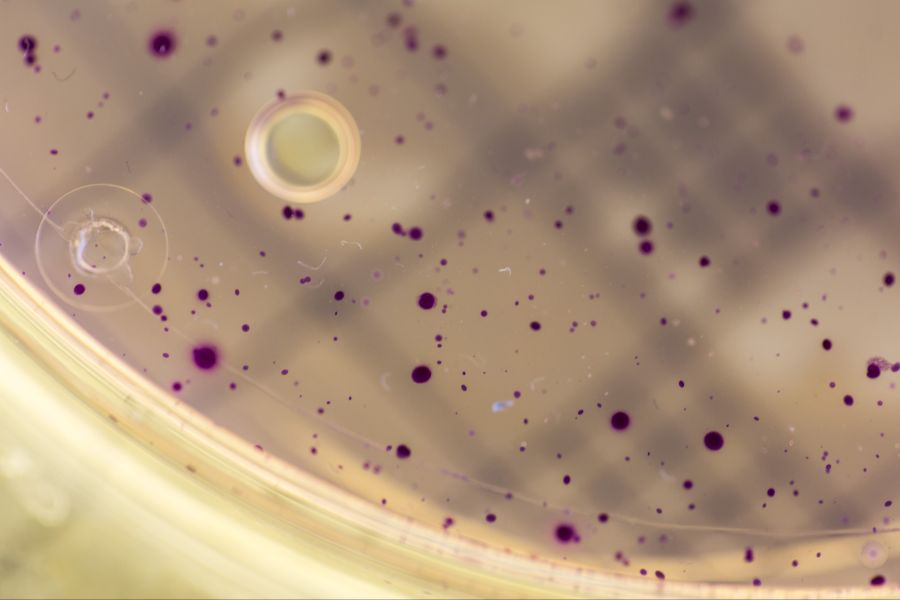
keime

Deshalb bleibt Aarauer Ekel-Beiz anonym
Eine Pizzeria fällt bei Inspektionen mehrfach negativ auf. Die Öffentlichkeit darf aber nur erfahren, dass sich das Lokal im Bezirk Aarau befindet.

Das Wichtigste in Kürze
- Ein Restaurant im Bezirk Aarau ist mehrfach durch eine Kontrolle gerasselt.
- Der Betreiber wurde gebüsst. Um welches Lokal es sich konkret handelt, bleibt unbekannt.
- Die Namen solcher Beizen zu nennen, hält der Branchenverband nicht für zielführend.
Im Bezirk Aarau scheint es eine echte Ekel-Pizzeria zu geben. Denn gemäss eines Strafbefehls wurde der Betrieb dreimal im vergangenen Jahr kontrolliert. Jedes Mal wurden Missstände festgestellt.
Das kleinste Übel waren wohl offen ausgelegte Backwaren, bei denen die Herkunftsdeklaration fehlte.
Schlimmer dürfte jedoch anderes sein, was das Amt für Verbraucherschutz dort feststellte. Darunter: mehrfach überschrittene Keimrichtwerte, Zigarettenstummel im Lagerraum, ungenügend ausgerüstete Handwaschmöglichkeit. Das ist nur ein Auszug.
Der Geschäftsführer kümmerte sich jeweils nicht ausreichend darum, die Probleme zu beheben. Wegen mehrfacher Übertretung des Lebensmittelgesetzes wurde er zu einer Busse von 3000 Franken verurteilt. Darüber hinaus muss er auch Gebühren in Höhe von 700 Franken berappen.
Über den Fall berichtete die «Aargauer Zeitung». Was jedoch beim ein oder anderen für Kopfschütteln gesorgt haben dürfte: Um welches Lokal es sich konkret handelt, bleibt unbekannt.
Verbraucherschutz hat Schweigepflicht
Das Gesetz untersagt es, solche Betriebe «an den Pranger zu stellen». Entsprechend kann das für die Kontrollen zuständige Amt für Verbraucherschutz (AVS) nur bedingt zu dem Fall weiter Auskunft geben.
Auf Nau.ch-Anfrage schreibt der Sektionsleiter des Lebensmittelinspektorats, Thomas Stadelmann: «Bezüglich Lebensmittelrecht wird der Lebensmittelbetrieb weiterhin risikobasiert kontrolliert.»
Er verweist darauf, dass nach Artikel 56 des Lebensmittelgesetzes (LMG) die Mitarbeitenden des AVS der Schweigepflicht unterstehen. Allgemein würde man lediglich in einem Jahresbericht über die Lage informieren.
Zufrieden mit der Anonymität fehlbarer Betriebe ist beileibe nicht jeder. So gab es etwa im vergangenen Jahr eine Interpellation der Grossräte Daniele Mezzi (Mitte) und Emanuel Suter (SVP).
In dieser hiess es zum Beispiel: «Die Nichtveröffentlichung der Namen von Betrieben mit wiederholten Hygienemängeln steht aus Sicht der Interpellanten im Widerspruch zum öffentlichen Interesse an Transparenz und Sicherheit.»
Als «zweckmässig» bezeichnete der Regierungsrat daraufhin in seiner Antwort das geltende Recht. Er sehe keine Notwendigkeit für mehr Transparenz für Konsumentinnen und Konsumenten.
Ebenso macht die Regierung auf das Risiko aufmerksam, dass bei Veröffentlichung zusätzlicher Information «diese verzerrt oder falsch weiterverbreitet werden». Hetze und Empörung gegen einzelne Betriebe oder Personen würde so begünstigt.
Gastro-Verband ebenso gegen öffentlichen «Pranger»
Ähnlicher Ansicht ist auch der Branchenverband «GastroAargau». Präsident Bruno Lustenberger sagt zu Nau.ch: «Wir denken, dass es nicht zielführend ist, die Betriebe zu veröffentlichen.»
Der Betrieb selbst könne nichts dafür, argumentiert er. Es sei der Betriebsleiter oder allenfalls der Küchenchef, der seinen Job nicht erledigt habe. Das «komplett ramponierte» Image würde es bei einem Wechsel dann unmöglich machen, den Betrieb weiter aufrechtzuerhalten.
Skandinavier als Vorbild?
In Dänemark etwa existiert bereits ein System, welches für mehr Transparenz sorgen soll. Dort zeigt ein Smiley, wie ein Betrieb die gesetzlichen Bestimmungen einhält. Verbandspräsident Lustenberger findet, dies habe sich nicht bewährt.
Auch ein möglicher «Generalverdacht», in diesem Fall gegenüber allen Pizzerien im Bezirk Aarau, überzeugt ihn nicht: «Kann zwar sein, aber wie bereits gesagt, kann der Betrieb ja nichts dafür. Wenn jemand einen Autounfall hat, ist in der Regel auch nicht das Auto schuld, sondern der Lenker.»
Er hält es für zielführend, fehlbare Betreiber «gebührend zu verurteilen» und in schweren Fällen ein Betreiberverbot auszusprechen. Dies sei im Kanton Aargau möglich, da dort ein Fähigkeitsausweis zum Führen einer Gaststätte benötigt wird.
Tatsächlich hat das Amt für Verbraucherschutz ebenso die Befugnis, ein Etablissement sofort zu schliessen. Dies, wenn die Verhältnisse «die öffentliche Gesundheit unmittelbar und in erheblichem Masse gefährden», schreibt Thomas Stadelmann.
Ansonsten werden etwa Massnahmen zur Behebung von Mängeln verfügt. Auch die Benutzung von Räumen und Einrichtungen kann zeitweise oder permanent verboten werden.








